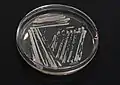
Gærsvampen Saccharomyces cerevisiae, der vokser i agar i en petriskål.

Svampe
Svampe (Fungi) er en stor gruppe af organismer, der oprindeligt blev anset for at være en form for planter, men nu er samlet i et selvstændigt rige, svamperiget, der har vist sig at være mere beslægtet med dyreriget end med planteriget.[1][2]. Blandt de 100.000 kendte arter er mange vigtige nedbrydere af dødt organisk materiale. Andre er parasitter, der lever af levende planter og dyr, eller lever i symbiose med planter ved hjælp af såkaldt mykorrhiza. Svampe er desuden kendt for undertiden at indeholde giftige og psykedeliske stoffer.
 "Svamp" omdirigeres hertil. For andre betydninger af Svamp, se Svamp (flertydig).
"Svamp" omdirigeres hertil. For andre betydninger af Svamp, se Svamp (flertydig).
| Svampe | |
|---|---|
 Fra øverst til venstre: rød fluesvamp, frynset skjoldbæger, Aspergillus fumigatus, piskesvampe og mug | |
| Videnskabelig klassifikation | |
| Overdomæne | Biota |
| Domæne | Eukaryoter (Eucaryota) |
| (urangeret) | Unikonta |
| (urangeret) | Opisthokonta |
| Rige | Fungi |
| Synonymer | |
| Mycota | |
| Hjælp til læsning af taksobokse | |

Selvom svampe er meget almindelige over hele verden, lægges der ikke meget mærke til dem, fordi mange er mikroskopiske og lever et skjult liv f.eks. i jorden, på dødt organisk materiale eller som del af en symbiose med planter, dyr eller andre svampe. Nogle arter af svampe bemærkes, når de for at formere sig danner frugtlegemer (fx paddehatte) eller som skimmel- og mugsvampe dækker en overflade og spreder deres sporer.
Den disciplin af biologien, der beskæftiger sig med svampe, kaldes mykologi. Mykologi blev tidligere betragtet som en gren af botanik, fordi svampe henregnedes til planteriget.
Levevis


Svampe lever først og fremmest af at nedbryde organisk materiale. Eksempelvis er tåge-tragthat en af de vigtigste nedbrydere af blade, grene og kviste. Svampe hører sammen med bakterier til de vigtigste nedbrydere i naturen, og er en nødvendig forudsætning for at stofkredsløbet kan opretholdes. Et krav for at svampesporerne kan spire er en vedholdende fugtighed, hvilket f.eks. er opfyldt i jorden.
Svampe lever især af sukker f.eks. i form af cellulose som nedbrydes til simple sukkermolekyler og derefter fordøjes af svampens mycelium. Det meste døde plantevæv består netop af cellulose, og svampe fordøjer derfor ofte plantevæv. Langt de fleste svampe kan leve i både iltfri (fx som gærfase) og i iltrige miljøer.
Drøvtyggere (fx får og tamkvæg) fordøjer planternes cellulose ved hjælp af mikroorganismer som bakterier og svampe i en af deres dertil indrettede maver. Her nedbrydes cellulose til glukose og omdannes til fedtsyrerne eddikesyre, propionsyre og smørsyre, hvilket drøvtyggerne så lever af.
Symbiose
Mange svampe har en form for symbiose med organismer fra andre biologiske riger, fx planter, dyr eller bakterier.[3][4][5] Symbiosen kan for den anden organisme (værten) enten være gavnlig eller skadelig (i nogle tilfælde dog ingen af delene). Der kan i relationen mellem svamp og vært altså både være tale om mutualisme, parasitisme og kommensalisme.[6][7][8] Laver er en symbiose mellem svampe og visse alger.
Symbiose med planter
Symbiosen med planter ved hjælp af mykorrhiza, hvor svampens mycelium gror ind i plantens rødder, er en af de bedst kendte relationer mellem planter og svampe, og den er af stor betydning for planters vækst og livsmuligheder i mange økosystemer. Over 90% af alle plantearter har symbiose med svampe, og kan være afhængige af dette for at overleve.[9] Det øger ofte plantens optagelse af uorganiske forbindelser, f.eks. nitrat og fosfat fra steder hvor der er lave koncentrationer af disse vigtige næringsstoffer.[10][11]
Morfologi
.jpg.webp)
Svampe kan være encellede (fx gærsvampe) eller flercellede. De flercellede består af hyfer, der er lange celletråde typisk omkring en hundrededel millimeter i diameter.[12] Disse hyfer er forgrenede og danner tilsammen det såkaldte mycelium, der helt kan gennemvæve det medium (fx jord eller planteved) som det vokser i. Svampen sender enzymer ud i omgivelserne som muliggør at de større organiske forbindelser nedbrydes til mindre dele, således at de bliver tilpas små til at kunne optages gennem cellevæggene. Det er på denne måde svampen optager næring.
Det er for de flercellede svampe myceliet, der kan siges at være selve svampeindividet. Det samme individ (eller genetisk ens gruppe af individer) kan med tiden udbrede sig over et meget stort område og opnå en høj alder. F.eks. er en genetisk ens gruppe af individer af arten mørk honningsvamp (Armillaria ostoyae), der vokser i en nåleskov i Oregon (USA), blevet målt at dække et område på 900 hektar og være mindst 1900 år gammel.[13]
I modsætning til det næsten skjulte mycelium kan svampens eventuelle frugtlegeme ses over jorden som fx en paddehat.
Taksonomi


| Svampe |
| |||||||||||||||||||||||||||||||||||||||||||||||||||
Kladogram, der viser svampenes inddeling i underriger/rækker.[18][19]
I alt er navngivet omkring 100.000 forskellige arter af svampe, men der findes måske ti gange så mange, der stadig er ubeskrevede.[20][21] Svampene inddeles i seks forskellige rækker/underriger.[18][19]
Dikarya: Basidiesvampe og sæksvampe
Langt de fleste arter (>97%) findes i underriget Dikarya som inkluderer de to beslægtede rækker basidiesvampe (Basidiomycota) og sæksvampe (Ascomycota). Livscyklus hos de to svampegrupper består af en lang haploid og en kort diploid fase, hvor der ind imellem er indskudt en tokernet (dikaryotisk) fase.[22][23]
Disse svampegrupper har navn efter det sted på svampene, hvor sporerne dannes. Hos basidiesvampe sidder sporerne fire sammen for enden af et såkaldt basidie, mens de hos sæksvampe dannes i sække med otte sporer i hver. Hos en basidiesvamp som champignon sidder basidierne tæt sammen på lameller på hattens underside, og her kan der i løbet af få dage dannes 10-20 milliarder sporer.[12]
Hos begge disse rækker danner nogle arter frugtlegemer medens andre arter er mikrosvampe. De største af disse frugtlegemer er de såkaldte hatsvampe hos basidiesvampene.
- Basidiesvampe, Basidiomycota kan have frugtlegemer som fx lamelsvampe, rørhatte, poresvampe. Omkring 32.000 kendte arter.
- Sæksvampe, Ascomycota kan ligeledes have frugtlegemer som fx morkler eller bægersvampe. Omkring 64.000 kendte arter.
Øvrige rækker
De øvrige rækker rummer kun mikrosvampe.
- Mucoromycota former en søstergruppe til Dikarya og inkluderer mange mikrosvampe, der lever sammen med planter. En inddeling indenfor denne række er Glomeromycotina, der er mikrosvampe, der danner arbuskulært mykorrhiza. Kun cirka 169 arter kendes. Denne gruppe var traditionelt en del af formgruppen koblingssvampe (Zygomycota).
- Zoopagomycota er en gruppe mikrosvampe hvoraf mange lever som parasitter.
- Chytridiomyceta er et underrige, hvis medlemmer formerer sig med zoosporer, og inkluderer tre rækker, der totalt rummer mindre end 1000 arter. En række er Piskesvampe, Chytridiomycota, en gruppe mikrosvampe, der mest lever i vand. En anden række er Neocallimastigomycota, mikrosvampe, der lever i drøvtyggeres maver. Kun cirka 20 arter.
- Blastocladiomycota er mikrosvampe der formerer sig med zoosporer (selvbevægelige, ukønnede sporer med flageller) og alternerer mellem haploide og diploide generationer (de har en såkaldt haplodiplontisk livscyklus). Kun cirka 179 arter.
- Opisthosporidia udgør de mest basale svampe og er en muligvis parafyletisk gruppe (uden fælles stamfader) af endoparasitter (indvendige snyltere). En gruppe her er Microsporidia, encellede parasitter i dyr. Over tusind kendte arter.
Sammenligning med dyr og planter
| Eukaryoter |
| |||||||||||||||||||||||||||||||||||||||
Kladogram der viser svampes slægtskab
med bl.a. dyr og planter.[24]
Indenfor den nyere biologiske taksonomi henregnes svampe nu til et selvstændigt rige (blandt 6-7 andre riger), fordi bl.a. genetiske undersøgelser har vist, at svampe er nærmere beslægtet med dyr end med planter. Hvor man betegner et områdes planter som "flora" og dyreliv som "fauna", betegnes et områdes svampeliv som "funga".
Før indførelsen af molekylære metoder for fylogenetisk analyse betragtede taksonomikere svampe som hørende til planteriget på grund af lighederne i vækst: både svampe og planter er hovedsageligt immobile og ligner hinanden i generel morfologi og voksested. Ligesom planter vokser svampe ofte i jord, og danner for nogle svampes vedkommende kraftige frugtlegemer, der kan ligne visse planter såsom mosser. I dag anses svampe for at høre til et selvstændigt rige - adskilt fra både planter og dyr, som de formodes at have udviklet sig fra for en milliard år siden.[25][1][2] Visse morfologiske, biokemiske og genetiske træk har de til fælles med andre organismer, mens andre er unikke for svampe og dermed adskiller dem klart fra andre riger.
- Fælles træk med dyr: Svampe mangler grønkorn og er heterotrofe organismer, der derfor kræver allerede dannet organisk materiale som energikilde.[26]
- Fælles med planter: Svampe har i deres celler vakuoler[27] og cellevægge[28]. De kan formere sig både kønnet og ukønnet og ligesom lavere planter (såsom bregner og mosser) frembringe sporer. Ligesom mosser og alger har svampe typisk haploide cellekerner.[29]
- Unikke træk: Nogle arter lever som encellede gærsvampe, der formerer sig ved knopskydning eller binær fission. Der findes svampe, der er i stand til at skifte mellem en gærfase og en fase med trådformede cellerækker (hyfer) som reaktion på ydre forhold.[30] Svampenes cellevægge er sammensat af glucaner og kitin. Selv om kitin også findes hos planter og glucaner i exoskelettet af leddyr,[31][32] så er svampe de eneste organismer, der kombinerer disse to strukturmolekyler i deres cellevæg. I modsætning til planter og ægsporesvampe indeholder svampes cellevægge ikke cellulose.[33]
Selv om svampene traditionelt medtages i mange, botaniske undervisningsforløb og lærebøger, anses de nu for at være nærmere beslægtede med dyr end med planter,[1][2] og de bliver anbragt sammen med dyrene i den monofyletiske gruppe, opisthokonta (af græsk: opísthios = bagved, kontos = pol, flagel).[34] Undersøgelser af den molekylære fylogenetik støtter svampenes oprindelse i en monofyletisk gruppe.[35].
Tidligere taksonomi
Traditionelt var svampene inddelt i fire grupper: basidiesvampe, sæksvampe, koblingssvampe og "imperfekte svampe".[36] Til midten af 1900-tallet blev svampene regnet til planteriget og ofte kaldt kryptogamer, men man erkendte på det tidspunkt, at svampene var så afvigende fra andre organismer, at de skulle have deres eget rige, svamperiget. Siden er dette blevet bekræftet af undersøgelser på celleniveau og senest også molekylære studier.[21]
Svampenes taksonomi er siden blevet revideret flere gange, særligt under indtryk af den nyeste forskning, der er baseret på sammenligninger af DNA. Disse igangværende fylogenetiske undersøgelser vender ofte op og ned på de klassificeringer, der bygger på ældre og til tider noget mindre præcise metoder. Den gamle klassifikation var baseret på morfologiske metoder og biologiske artsafgrænsninger, der byggede på eksperimentelle krydsningsforsøg.[37]
En omfattende ny klassificering af svamperiget, der blev gennemført i 2007, var resultatet af et storstilet forskningssamarbejde, der inddrog snesevis af svampespecialister og andre forskere, der arbejdede med svampenes taksonomi.[35] Den opstillede syv rækker, hvoraf de to – sæksvampe og basidiesvampe – blev placeret i en gren, som rummer underriget Dikarya. [18][19] I takt med at genomer for flere og flere svampe er blevet kortlagt er er denne klassificering efterfølgende blev udviklet yderligere, og omfatter nu kun seks rækker[18][19]
Der forekommer stadig hyppige navneændringer på alle niveauer fra og med artsniveau og opefter. Blandt mange forskere gøres der anstrengelser for at opbygge en fælles og mere sammenhængende nomenklatur, som man kan bede folk om at bruge.[35][38] Svampearterne kan tilmed have flere forskellige videnskabelige navne alt efter deres livscyklus og formeringsmåde (kønnet eller ukønnet). Netsteder som Index Fungorum og ITIS bringer lister over de gældende navne for svampearter (med henvisning til ældre synonymer).
Man har tidligere klassificeret andre organismer som svampe, f.eks.:
- Svampedyr (tidligere slimsvampe) (Mycetozoa) er nu en infrarække af protozoer, i rækken Amoebozoa.
- Ægsporesvampe (Oomycota, Oomycetes) er en gruppe svampelignende mikroorganismer, der nu tilhører riget Stramenopila.
Formgrupper
Svampe kan inddeles i såkaldte formgrupper, der forener arter med ens udseende, hvilket også kan omfatte mikroskopiske træk. Eksempler på formgrupper:
- Lamelsvampe er basidiesvampe med lameller på frugtlegemet. Nogle lamelsvampe er dog beslægtet med rørhatte og hører til rørhat-ordenen[21]
- Poresvampe er basidiesvampe med porer på undersiden af frugtlegemet, men tilhører flere forskellige svampefamilier, der ikke er indbyrdes beslægtede.
- Trøfler har underjordiske, knoldformede frugtlegemer og passiv sporespredning.
- Koblingssvampe (Zygomycota) er svampe, der i deres kønnede formering anvender såkaldte zygosporer. Denne formgruppe er indtil for nylig også blevet regnet som en række indenfor svampene. Gruppen omfatter eksempelvis mikrosvampe såsom insektskimmel.[21]
- Fungi imperfecti (imperfekte svampe) er svampe, hvor der ikke kendes kønnet formering og hvor kun det anamorfe stadie er kendt. Et eksempel på en sådan "uperfekt svamp" er mug.
Arterne indenfor en formgruppe er ikke nødvendigvis beslægtet med hinanden og nogle arter tilhører flere formgrupper. Eksempelvis har det vist sig at den samme art både kan have anamorfe og teleomorfe livsstadier, som det er tilfældet for arter af slægten Trichoderma. På samme måde har nogle arter både et gærstadie og et andet stadie med hyfer.
Teleomorfe og anamorfe svampe
Indenfor mykologien findes to uafhængige måder at klassificere svampe. Den ene måde omfatter svampe med kønnet formering (typisk med frugtlegemer), mens den anden omfatter svampe med ukønnet formering, hvorfra ingen frugtlegemer kendes (imperfekte svampe), det vil sige henholdsvis teleomorfe og anamorfe svampe. Mykologer klassificerer teleomorfer efter deres slægtskab (fylogeni), mens anamorfer klassificeres i såkaldte formgrupper, der ikke siger noget om deres slægtskab. Disse formgrupper af anamorfer benævnes parallelt med det sædvanlige system, der indeholder rækker, klasser, ordener, familier, slægter og arter.[39]
Den samme svamp kan både bestå af en teleomorf og af en eller flere anamorfer. Den kaldes samlet for holomorfen. Dette betyder, at svampen kan være navngivet (ubevidst) både som teleomorf og anamorf. F.eks. er den svamp, hvis teleomorf kaldes rødbrun kødkernesvamp (Hypocrea rufa) identisk med den anamorfe svamp Trichoderma viride. Ved hjælp af sammenligninger af svampes DNA har man kunnet artsbestemme en række selvstændige arter, som tidligere blev anset for samme art. Samme teknik er benyttet til at knytte flere anamorfer sammen med deres teleomorfer, se slægten Trichoderma.[40][41]
Formering


Svampes formering er kompleks, idet den afspejler den store variation i levevis og genotype indenfor svamperiget. Det skønnes at en tredjedel af alle svampe formerer sig på mere end en måde. F.eks. kan formeringen i en arts livscyklus foregå i to helt forskellige typer af stadier. Nemlig i et teleomorft stadie med kønnet fomering, hvor sporer typisk spredes fra et frugtlegeme, eller i et anamorft stadie med ukønnet formering og altid uden frugtlegeme. Det er forhold i miljøet, der udløser disse genetisk bestemte udviklingsstadier, og som medfører dannelsen af strukturer (fx teleomorfe eller anamorfe) beregnet for enten kønnet eller ukønnet formering.
Frugtlegemet hæver sporerne op, så de nemmere spredes med vinden. Sporerne fra den kønnede formering kaldes meiosporer. Der findes dog mange svampearter, som ikke producerer frugtlegemer, de såkaldt imperfekte svampe. Hos disse svampe kan der også udvikles sporer. Hos rækken sæksvampe dannes fx såkaldte konidier (mitosporer) i det anamorfe stadie.
Køn
Svampe findes hverken som hanner eller hunner, fordi kønscellerne er ens i størrelse og udseende, såkaldte isogameter. Hos mange arter, fx Phycomyces blakesleeanus, hvor der findes to typer kønsceller, kaldes de i stedet plus-køn (med sexP-genet) og minus-køn (med sexM)[42][43][44]. Andre arter har mere end to køn (parringstyper), idet nogle arter har fire, otte eller hos arten kløvblad (Schizophyllum commune) helt op til 28000 forskellige køn. Mange køn har den fordel, at sandsynligheden er meget stor for, at to individer er af forskelligt køn, når de mødes (det vil sige når hyfetråde fra to forskellige individer mødes).[45][46]
Kønnet formering er dog mindre almindelig end ukønnet formering blandt svampe. [47]
Anvendelse og økonomisk betydning
Når man taler om anvendelse af svampe, tænker de fleste på "storsvampe" som en direkte kilde til mad, som fx (champignoner og trøfler). Dette har en vis økonomisk betydning i f.eks. Østeuropa og Østasien, mens den økonomiske betydning i Danmark er ret lille.
Derimod er der mikroskopiske svampe af uhyre stor økonomisk betydning, også i Danmark. Disse falder groft sagt i fire grupper:
- Fødevareproduktion, f.eks. som hævemiddel til bagning eller som gæringsmiddel i forskellige fødevarer som øl og vin. Gærsvampe fordøjer normalt sukker og cellulose uden brug af atmosfærisk ilt, og i en menneskestyret proces kaldes dette for alkoholfermentering.
- Øl, cider og vin er resultatet af, at visse typer af gærsvampe har fordøjet sukker og omdannet meget af det til ætanol (sprit). Dog kan gæren også utilsigtet indeholde arter af gærsvampe, som omdanner noget af sukkeret til det giftige træsprit.
- Hævningen hos de brødtyper, hvor gærsvampen enten tilsættes som "ren" gær eller som surdej, fungerer ved at gærsvampe ligesom i øl, vin og cider omdanner sukker til ætanol. Under hævningsprocessen svulmer brødet op på grund af gærsvampenes udskillelse af carbondioxid (CO2) og dejens klæbrige konsistens. Carbondioxid forbliver i dejens små hulrum. Når brødet bages fordamper ætanolen og udgasser ligesom carbondioxiden, mens brødet til sidst stivner og slår små revner.
- Blåskimmeloste fremstilles, i modsætning til alkoholfermentering, i iltrige omgivelser ved, at man poder ost med svampen blåskimmel, hvilket giver osten dens særlige, kraftige blåskimmelsmag.
- I de tilfælde hvor halm, brød, frugter, grøntsager og korn mugner, skyldes det andre og normalt giftige svampetyper.
- Medicinsk anvendelse. Svampe er længe blevet anvendt til mange forskellige formål, f.eks. , Siden 1940'erne er svampe som fx penselskimmel (Penicilium sp.) blevet anvendt i produktionen af antibiotika
- Bioteknologisk anvendelse. Mikroskopiske svampe anvendes som producenter af enzymer i industrien , fx til anvendelse i vaskemidler.
- Svampe anvendes også som biologiske pesticider imod ukrudt, plantesygdomme eller skadevoldende insekter.
Nogle svampe kan have negativ betydning ved at nedbryde materialer og bygninger, eller ved at være årsag til sygdomme blandt mennesker eller husdyr, fx gærsvampesygdomme. Tab af afgrøder som følge af svampesygdomme eller råd kan have stor indflydelse på den lokale fødevareforsyning og økonomi.
Svampe i Danmark
Svampe er en af de mest artsrige grupper af organismer i den danske natur. Det skønnes er der findes omkring 8000 arter i Danmark, men mange er endnu ikke registreret. Af disse kan 3000 arter betegnes som "storsvampe", der har frugtlegemer større end 10 millimeter. De fleste af disse storsvampe findes i skove. Den rigeste funga findes i gamle naturskove, hvor dødt ved ikke fjernes, som det er tilfældet hvor der drives intensivt skovbrug.[48]
Svampes frugtlegemer ses i Danmark især sidst på sommeren og om efteråret. De behøver fugtigt vejr igennem flere dage, for at kunne udvikles. Små arters frugtlegemer kan dannes på få timer, mens de større arters normalt udvikles på et par dage. Hvis vejrforholdene er gunstige kan frugtlegemer herefter stå i flere uger. De hårde, konsolformede poresvampe kan dog blive flere år gamle og danner nye porelag året rundt.[49]
Spiselige svampe
Svampe har været kendt af mennesker som spiselige i tusinder af år, bl.a. i Kina.[50] I antikkens Rom kendte man ligeledes til både spiselige og giftige svampe, og man troede på den tid, at de var "udvækster" fra fugtig jord. Først i 1710 opdagede italieneren Pier Antonio Micheli, at svampe formerer sig ved sporer, og han beskrev en lang række arter. Det er dog hollænderen Christian Hendrik Persoon (1761–1836) og svenskeren Elias Fries (1794-1878), der regnes som mykologiens grundlæggere.[51][49]
En del svampe, eller rettere deres frugtlegemer, er spiselige. Der findes en stor variation i smag, farve og konsistens. Som friske indeholder svampe typisk omkring 90% vand, 3-4% protein, 3-4% kulhydrat, 1% mineraler, 0,2% fedt og nogle få fibre. Der er således mere protein i svampe end i grønsager, men mindre end i kød. Indholdet af vitaminer er stort med f.eks. både C, D, B1, B2, B6, niacin og folinsyre samt forskellige mineraler og sporstoffer, dog ikke kalk.[12]
Svampe er tungt fordøjelige for mennesker og bør derfor tygges grundigt.[12]
Giftige svampe
Svampe er i stand til at danne meget komplicerede organiske forbindelser. En række svampe danner stoffer, der ved indtagelse, kan angribe de menneskelige organer, fx nyrer og lever, hvilket i nogle tilfælde kan medføre døden. I Danmark er den almindeligste årsag til forgiftninger stoffet alfa-amanitin, der bl.a. findes hos hvid og grøn fluesvamp. Andre giftstoffer er orellanin og gyromitrin, der findes hos henholdsvis giftslørhatte[52] og stenmorkel (Gyromitra esculentia). Endelig findes stoffet muscarin, der virker som en nervegift på hjertet. Det findes hos mange svampearter, som f.eks. rød fluesvamp, men kun i dødelig dosis hos visse trævlhatte (Inocybe).[53] Muscarin kan neutraliseres med atropin.[49]
Mange svampe indeholder desuden betydelige mængder af tungmetaller, især cadmium. Dette er målt i arterne gulhvid champignon og landsby-champignon, men optages muligvis ikke af mennesker, der spiser disse svampe.[49]
Andre svampe har desuden en hallucinerende virkning som f.eks. psilocybinsvampe uden dog at være direkte giftige.
Billeder
 Madsvampe sælges ofte som tørrede. Foto: Aka
Madsvampe sælges ofte som tørrede. Foto: Aka Stinksvamp (Phallus impudicus).
Stinksvamp (Phallus impudicus). Østershat (Pleurotus ostreatus)
Østershat (Pleurotus ostreatus) Spiselig rørhat (Boletus edulis), også kaldet Karl Johan, er en almindelig madsvamp.
Spiselig rørhat (Boletus edulis), også kaldet Karl Johan, er en almindelig madsvamp. Skimmelsvampen Aspergillus niger på et løg.
Skimmelsvampen Aspergillus niger på et løg. Violet hekseringshat ses her tydeligt vokse i en såkaldt heksering.
Violet hekseringshat ses her tydeligt vokse i en såkaldt heksering.
Rodfordærver (Heterobasidion annosum) er meget udbredt på den nordlige halvkugle.
Rodfordærver (Heterobasidion annosum) er meget udbredt på den nordlige halvkugle. Kinesisk snyltekølle (Ophiocordyceps sinensis) er en parasit på larver af humleæder. Til slut "mumificeres" larven af svampen.
Kinesisk snyltekølle (Ophiocordyceps sinensis) er en parasit på larver af humleæder. Til slut "mumificeres" larven af svampen._Fuckel_206884.jpg.webp) Sortbæger (Pseudoplectania nigrella). Et eksempel på frugtlegemet af en sæksvamp.
Sortbæger (Pseudoplectania nigrella). Et eksempel på frugtlegemet af en sæksvamp. Den bioluminiscente Mycena chlorophos vokser i subtropisk Sydøst-Asien, Australien og Brazilien
Den bioluminiscente Mycena chlorophos vokser i subtropisk Sydøst-Asien, Australien og Brazilien
Noter
- Baldauf SL, Palmer JD (1993) Animals and fungi are each other's closest relatives: congruent evidence from multiple proteins. Proceedings of the National Academy of Sciences U.S.A. 90: 11558-62. doi: 10.1073/pnas.90.24.11558.
- Baldauf SL (1999) A Search for the Origins of Animals and Fungi: Comparing and Combining Molecular Data. (Webside ikke længere tilgængelig) American Naturalist 154: S178-S188. doi: 10.1086/303292.
- Aanen DK. (2006). "As you reap, so shall you sow: coupling of harvesting and inoculating stabilizes the mutualism between termites and fungi". Biology Letters. 2 (2): 209-212. doi:10.1098/rsbl.2005.0424. PMC 1618886. PMID 17148364.
- Nikoh N, Fukatsu T. (2000). "Interkingdom host jumping underground: phylogenetic analysis of entomoparasitic fungi of the genus Cordyceps". Molecular Biology and Evolution. 17 (4): 629-638. PMID 10742053.
- Perotto S, Bonfante P. (1997). "Bacterial associations with mycorrhizal fungi: close and distant friends in the rhizosphere". Trends in Microbiology. 5 (12): 496-501. doi:10.1016/S0966-842X(97)01154-2. PMID 9447662.
- Arnold AE, Mejía LC, Kyllo D, Rojas EI, Maynard Z, Robbins N, Herre EA. (2003). "Fungal endophytes limit pathogen damage in a tropical tree". Proceedings of the National Academy of Sciences USA. 100 (26): 15649-15654. Bibcode:2003PNAS..10015649A. doi:10.1073/pnas.2533483100. PMC 307622. PMID 14671327.
{{cite journal}}: CS1-vedligeholdelse: Flere navne: authors list (link) - Paszkowski U. (2006). "Mutualism and parasitism: the yin and yang of plant symbioses". Current Opinion in Plant Biology. 9 (4): 364-370. doi:10.1016/j.pbi.2006.05.008. PMID 16713732.
- Hube B. (2004). "From commensal to pathogen: stage- and tissue-specific gene expression of Candida albicans". Current Opinion in Microbiology. 7 (4): 336-341. doi:10.1016/j.mib.2004.06.003. PMID 15288621.
- Bonfante P. (2003). "Plants, mycorrhizal fungi and endobacteria: a dialog among cells and genomes". The Biological Bulletin. 204 (2): 215-220. doi:10.2307/1543562. JSTOR 1543562. PMID 12700157.
- Lindahl BD, Ihrmark K, Boberg J, Trumbore SE, Högberg P, Stenlid J, Finlay RD. (2007). "Spatial separation of litter decomposition and mycorrhizal nitrogen uptake in a boreal forest". New Phytologist. 173 (3): 611-620. doi:10.1111/j.1469-8137.2006.01936.x. PMID 17244056.
{{cite journal}}: CS1-vedligeholdelse: Flere navne: authors list (link) - van der Heijden MG, Streitwolf-Engel R, Riedl R, Siegrist S, Neudecker A, Ineichen K, Boller T, Wiemken A, Sanders IR. (2006). "The mycorrhizal contribution to plant productivity, plant nutrition and soil structure in experimental grassland". New Phytologist. 172 (4): 739-752. doi:10.1111/j.1469-8137.2006.01862.x. PMID 17096799.
{{cite journal}}: CS1-vedligeholdelse: Flere navne: authors list (link) - Politikens svampebog, Foreningen til Svampekundskabens Fremme, 1983. ISBN 87-567-3813-7
- Ferguson BA, Dreisbach TA, Parks CG, Filip GM, Schmitt CL. (2003). "Coarse-scale population structure of pathogenic Armillaria species in a mixed-conifer forest in the Blue Mountains of northeast Oregon". Canadian Journal of Forest Research. 33 (4): 612-623. doi:10.1139/x03-065.
{{cite journal}}: CS1-vedligeholdelse: Flere navne: authors list (link) - Rød gitterkugle. Danmarks svampeatlas.
- Spiselig morkel. Danmarks svampeatlas.
- Ursækkølle. Danmarks svampeatlas.
- Krølhåret pragtbæger. Danmarks svampeatlas.
- James TY, Stajich JE, Hittinger CT, Rokas A (2020) Toward a Fully Resolved Fungal Tree of Life. Arkiveret 5. oktober 2021 hos Wayback Machine Annual Review of Microbiology 74: 291-313. doi: 10.1146/annurev-micro-022020-051835.
- Li Y, Steenwyk JL, Chang Y, Wang Y, James TY, Stajich JE, Spatafora JW, Groenewald M, Dunn CW, Hittinger CT, Shen XX, Rokas A (2021) A genome-scale phylogeny of the kingdom Fungi. Current Biology 31: 1653-1665 doi: 10.1016/j.cub.2021.01.074.
- Skønnet på i alt 100.000 svampearter er fremkommet ved at lægge antallet af arter sammen række for række, baseret på tal fra 10. udgave af Dictionary of the Fungi (Kirk et al., 2008): Ascomycota, 64163 arter (s. 55); Basidiomycota, 31515 (s. 78); Blastocladiomycota, 179 (s. 94); Chytridiomycota, 706 (s. 142); Glomeromycota, 169 (s. 287); Microsporidia, >1300 (s. 427); Neocallimastigomycota, 20 (s. 463).
- www.danske-svampe.dk. "Svamperiget". Arkiveret fra originalen 3. september 2013. Hentet 2013-10-10.
- www.danske-svampe.dk. ""Sæksvampe"". Arkiveret fra originalen 9. april 2010. Hentet 2013-10-17.
- www.danske-svampe.dk. "Basidiesvampe". Arkiveret fra originalen 21. august 2010. Hentet 2013-10-17.
- Fylogenetik baseret på:
- Eichinger, L.; Pachebat, J.A.; Glöckner, G.; Rajandream, M.A.; Sucgang, R.; Berriman, M.; Song, J.; Olsen, R.; Szafranski, K.; Xu, Q.; Others, (2005). "The genome of the social amoeba Dictyostelium discoideum". Nature 435 (7038): 43-57. DOI:10.1038/nature03481.
- Steenkamp, E.T.; Wright, J.; Baldauf, S.L. (2006). "The Protistan Origins of Animals and Fungi". Molecular Biology and Evolution 23 (1): 93-106. DOI: 10.1093/molbev/msj011.
- Cavalier-Smith, T. (2003).Protist phylogeny and the high-level classification of Protozoa Arkiveret 21. august 2009 hos Wayback Machine, Europ. J. Protistol. 39, 338-348.
- Bruns T. (2006). "Evolutionary biology: a kingdom revised". Nature. 443 (7113): 758-761. Bibcode:2006Natur.443..758B. doi:10.1038/443758a. PMID 17051197.
- Alexopoulos et al., side 28–33.
- Shoji JY, Arioka M, Kitamoto K. (2006). "Possible involvement of pleiomorphic vacuolar networks in nutrient recycling in filamentous fungi". Autophagy. 2 (3): 226-227. PMID 16874107.
{{cite journal}}: CS1-vedligeholdelse: Flere navne: authors list (link) - Alexopoulos et al., side 31–32.
- Deacon J. (2005). Fungal Biology. Cambridge, Massachusetts: Blackwell Publishers. s. 58. ISBN 1-4051-3066-0.
- Alexopoulos et al., side 30.
- Alexopoulos et al., side 32–33.
- Bowman SM, Free SJ. (2006). "The structure and synthesis of the fungal cell wall". BioEssays. 28 (8): 799-808. doi:10.1002/bies.20441. PMID 16927300.
- Alexopoulos et al., side 33.
- Kamran Shalchian-Tabrizi, Marianna A. Minge, Mari Espelund, Russell Orr, Torgeir Ruden, Kjetill S. Jakobsen og Thomas Cavalier-Smith: Multigene phylogeny of choanozoa and the origin of animals i PLoS ONE, 2008, 3, 5 side 2098.
- David S. Hibbett m.fl.: A higher level phylogenetic classification of the Fungi Arkiveret 26. marts 2009 hos Wayback Machine i Mycological Research, 2007, 111, 5, side 509–47. (Kladogrammer efter side 97)
- C. Ferdinandsen (og F. Kølpin Ravn): opslaget Svampe i Salmonsens Konversationsleksikon 2.udgave, bind 22, 1930
- Palaeos: Fungi, med en introduktion til svampenes taxonomi, og med de seneste tvivlstilfælde.
- G.J. Celio, M. Padamsee, B.T. Dentinger, R. Bauer og D.J. McLaughlin: Assembling the Fungal Tree of Life: constructing the structural and biochemical database i Mycologia, 2006, 98, 6 side 850–59
- doctorfungus.org: Mould and actinomycetes identification Arkiveret 3. september 2013 hos Wayback Machine, side 3 om "Fungi Imperfecti".
- Hyde KD, McKenzie EHC, KoKo TW. (2011). Towards incorporating anamorphic fungi in a natural classification – checklist and notes for 2010. Mycosphere 2(1), 1–88.
- Priscila Chaverri and Gary J. Samuels (2003): Hypocrea/Trichoderma (Ascomycota, Hypocreales, Hypocreaceae): species with green ascospores Studies in Mycology 48: 1-116.
- Science Daily (10. januar 2008). "Evolution Of The Sexes: What A Fungus Can Tell Us" (engelsk).
- Side 36-37 i "Svampe" i Gamlin, L. og Vines, G.:"Livet på Jorden" i Videnskabens Verden-serien (7), 1987, Bonniers Bøger, ISBN 87-427-0258-5
- University of Sydney. "Mycology - Reproduction and Dispersal" (engelsk). Arkiveret fra originalen 2. oktober 2013. Hentet 2. oktober 2013.
- Bjørli Lehrmann: www.vestrehus.dk/
- Thomas J. Volk, Tom Volk's Fungus of the Month for February 2000 University of Wisconsin-La Crosse, 2000
- s. 154 i "Fungi" i Margulis' Five Kingdoms (1988): "Most fungi, even those that have sexual stages, can form spores directly – that is, without sex. In fact, most reproduce asexually more often than they do sexually."
- Danmarks Naturfredningsforening (2010) Danmarks natur 2010 - om tabet af biologisk mangfoldighed Arkiveret 20. oktober 2013 hos Wayback Machine, side 69-74.
- Edmund Garnweidner: Svampe oversat af Linda Bruhn Jørgensen. Gyldendal 1991. ISBN 87-01-30274-4.
- Eric Boa, FAO: Wild Edible Fungi: A Global Overview of Their Use and Importance to People Udgivet i Rom 2004. ISBN 92-5-105157-7.
- Christian Hendrik Persoon af Illinois Mycological Association. Arkiveret
- De i Danmark sjældne arter hvælvet gift-slørhat (Cortinarius orellanus) og puklet gift-slørhat (Cortinarius rubellus)
- Muscarin findes i livstruende dosis hos de almindelige arter almindelig trævlhat (Inocybe geophylla), gulbladet trævlhat (Inocybe rimosa) og giftig trævlhatog bleg tragthat (Inocybe erubescens).
Kilder og eksterne henvisninger
- Havenyt: Svampe i have og græsplæne Citat: "...De svampelegemer, der er synlige på overfladen er kun frugtlegemer (toppen af isbjerget) – selve svampen består af et stort underjordisk mycelium..."
- Netbiologen: Svampe
- Livet i jorden: Et tyndt lag rummer livets motor (Webarchive) – god information
- Havenyt: Hvad er det for nogle gule svampe i vores bed?
- Foreningen til Svampekundskabens Fremme
- Systema Naturae 2000: Kingdom Fungi Arkiveret 6. november 2003 hos Wayback Machine
- 7 August, 2000, Fantastic fungus find Citat: "...Researchers in the US have found what is probably the largest living organism on Earth....Scientists say it covers 890 hectares (2,200 acres) of land – an area equivalent to about 1,220 football pitches. The fungus is called Armillaria ostoyae, but is more popularly known as the honey mushroom. This particular specimen is calculated to be about 2,400 years old, although it could be two to three times this age...."
Litteratur
- Alexopoulos CJ, Mims CW, Blackwell M. (1996). Introductory Mycology. John Wiley and Sons. ISBN 0-471-52229-5.
{{cite book}}: CS1-vedligeholdelse: Flere navne: authors list (link) - Henderson's Dictionary of Biological Terms, 11th Edition, 1997, ISBN 0-582-22708-9, Longman
- Kirk PM, Cannon PF, Minter DW, Stalpers JA. (2008). Dictionary of the Fungi. 10th ed. Wallingford, UK: CAB International. ISBN 0-85199-826-7.
{{cite book}}: CS1-vedligeholdelse: Flere navne: authors list (link) - L. Margulis, Schwartz, K.V.:Five Kingdoms, An Illustrated Guide to the Phyla of Life on Earth, 2nd Edition, 1988, ISBN 0-7167-1912-6, Freeman.
- Jørgen Eilenberg, Annette Bruun Jensen og Nicolai Vitt Meyling: Insekternes svampesygdomme – fascinerende og nyttige i SVAMPE i verden, Jubilæumsskrift 2005, ISBN 87-984481-8-8
- Jens H. Petersen & Jan Vesterholt: De danske svampenavne, 1. udg. 1993, ISBN 87-984481-1-0 (PDFudgave 2003)